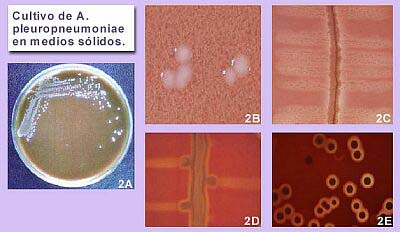
cultivo

| Curso de Enfermedades
Infecciosas Porcinas / Cultivo Galería Fotográfica - Actinobacillus pleuropneumoniae |
| Figura 2. Cultivo de A. pleuropneumoniae en medios sólidos. 2 A: colonias en agar chocolate. 2B: colonias en agar PPLO enriquecido con NAD; 2C: satelitismo en agar sangre. 2D. Efecto CAMP; 2E: colonias hemolíticas en la presencia sangre. |